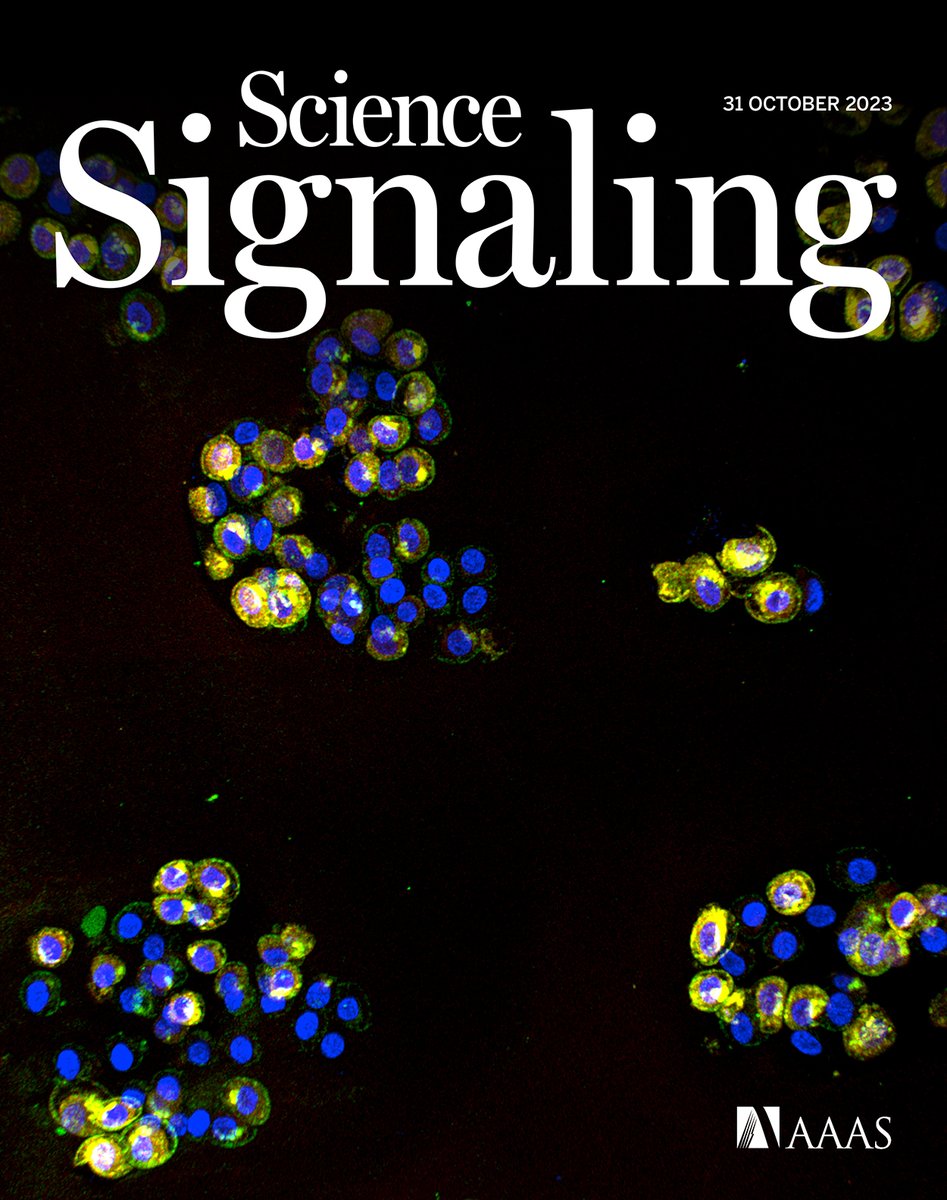
Loeser Lab Publishes Research Regarding a New Mechanism Underlying Cartilage Destruction in Osteoarthritis. Check out the new <a href="/scisignal/">Science Signaling</a> article and online cover from Miao et al. here: science.org/toc/signaling/…
<a href="/UNC_SOM/">UNC School of Medicine</a> @UNCResearch

veronica ulici
@veronicaulici
# Pathologist at URMC, # previous Path resident at Brown, # previous Surg path fellow at Mayo Clinic , # previous BST fellow at Cleveland Clinic
ID: 1332117927848501249
27-11-2020 00:24:35
102 Tweet
138 Followers
200 Following

Loeser Lab Publishes Research Regarding a New Mechanism Underlying Cartilage Destruction in Osteoarthritis. Check out the new Science Signaling article and online cover from Miao et al. here: science.org/toc/signaling/… UNC School of Medicine @UNCResearch

Registration is OPEN for our first annual Cleveland Clinic Soft Tissue Course!! Online and in-person options. Over 150 unique cases! Interactive discussion! clevelandcliniclabs.com/2024-cleveland… Scott Kilpatrick, MD Sanjay Mukhopadhyay Josephine Alex Isaacson, MD veronica ulici Sean R Williamson MD



FYI – Great comprehensive soft tissue course organized by Karen Fritchie and her colleagues at Cleveland Clinic next month (in person and virtual). - clevelandclinicmeded.com/live/courses/c…

Something I got reminded of today (old case) ➡️ LCIS involving collagenous spherulosis (pics 1-3). DDx. cribriform DCIS, adenoid cystic carcinoma. Last pic 👉🏻 LCIS involving intraductal papilloma w/ concurrent UDH. #BreastPath #PathTwitter Credits: UAB Pathology





Tweeples, please share this free video with your new pathology PGY1s. Very useful basic info on the key lung marker TTF-1 #pathology #pulmpath #ihcpath Jerad Gardner, MD Kamran Mirza MD PhD - کامران مرزا Vijay Shankar S Irene Sansano, MD Phd Raghavendra Pillappa @DrFNA Eduardo Alcaraz, MD PhD youtu.be/AoTDBfZdNMo?si…




Let me guess. You spend all your BST time focused on rare tumors, but you don't feel entirely comfortable with routine non-neoplastic BST pathology. We got you covered. jcp.bmj.com/content/early/… JClinPath_BMJ ClevelandClinicLabs Cleveland Clinic Pathology Residency Vikram Deshpande Nooshin Dashti MD John Reith

Excellent talk by Scott Kilpatrick, MD Pearls include ~ Necrosis in AVN should: 1) be grossly recognizable and 2) extend beyond the eburnated area. [Otherwise —> DJD with secondary necrosis] A team approach is needed for non-neoplastic musculoskeletal conditions too! #BSTPath
![Darcy A. Kerr (@darcykerrmd) on Twitter photo Excellent talk by <a href="/ScottBikeethan/">Scott Kilpatrick, MD</a>
Pearls include ~
Necrosis in AVN should: 1) be grossly recognizable and 2) extend beyond the eburnated area. [Otherwise —> DJD with secondary necrosis]
A team approach is needed for non-neoplastic musculoskeletal conditions too! #BSTPath Excellent talk by <a href="/ScottBikeethan/">Scott Kilpatrick, MD</a>
Pearls include ~
Necrosis in AVN should: 1) be grossly recognizable and 2) extend beyond the eburnated area. [Otherwise —> DJD with secondary necrosis]
A team approach is needed for non-neoplastic musculoskeletal conditions too! #BSTPath](https://pbs.twimg.com/media/GXxZHkSXEAAAuzc.jpg)

What’s rarer than hens’ teeth? Low-grade cartilaginous neoplasms of the mandible. This tumor masquerading as such on initial biopsy ended up being the *much more common* chondroblastic osteosarcoma. Great instructive case Nooshin Dashti MD John Reith #ISS2024 #BSTPath #ENTPath






